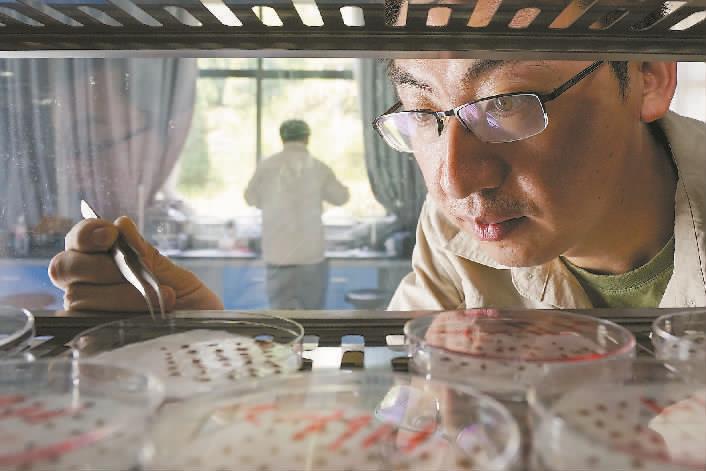

长江,作为中华民族的母亲河,如一条奔腾不息的巨龙,横贯神州大地,不仅孕育了源远流长、灿烂辉煌的中华文明,更承载着亿万人民对碧水清波、绿意盎然生态之美的无限憧憬与深情守望。近日,“2025年美丽长江生态文化作品征集宣传活动”获奖名单正式揭晓,为这条黄金水道再添一抹璀璨的文化亮色。
本次活动既是一场展现长江生态之美与文化底蕴的盛会,更是一次凝聚社会力量、共护长江母亲河的生动实践。
活动由重庆市生态环境局、中国环境报社、重庆市文学艺术界联合会主办,重庆市生态环境宣传教育中心、重庆市美术家协会、重庆市书法家协会、重庆市摄影家协会等多家单位承办。
为保证评选的公正性和专业性,活动邀请了业内知名专家组成评审团,经过两轮评审,评选出一等奖6名(每类作品各2名)、二等奖9名(每类作品各3名)、三等奖15名(每类作品各5名)以及优秀奖50名(作品类别不限)。
此次活动不仅为广大文艺爱好者提供了一个展现才华、抒发对长江热爱之情的平台,更通过一件件优秀作品,进一步唤醒社会公众对长江生态保护的重视,凝聚起共护长江、共建美丽家园的强大合力,让长江的生态之美、文化之韵在新时代绽放出更加夺目的光彩。
(本版仅为部分优秀作品展示,全部获奖作品可扫描二维码查看。)

▲摄影二等奖《长江源头》。杨艳(重庆市)

▼摄影一等奖《生态之城》。陈云元(重庆市)

▲摄影二等奖《风电星光灿烂》。吴雪(江苏省)

▲摄影三等奖《共抓大保护》组图选。何杰(安徽省)
▲摄影一等奖《崖柏“重生”——重庆雪宝山的答卷》组图选。张静(重庆市)

▲书法二等奖《长江古诗词十五首》。李永乐(中国澳门)

▲AI海报一等奖《绘制诗意长江》。张鸿鹭(重庆市)

▲AI海报一等奖《共生》。邱传曦(重庆市)

▲书法一等奖《长江赋》。
钱伟昭(广东省)

▲书法一等奖《浴风精舍陈坤篆刻》。陈坤(重庆市)




